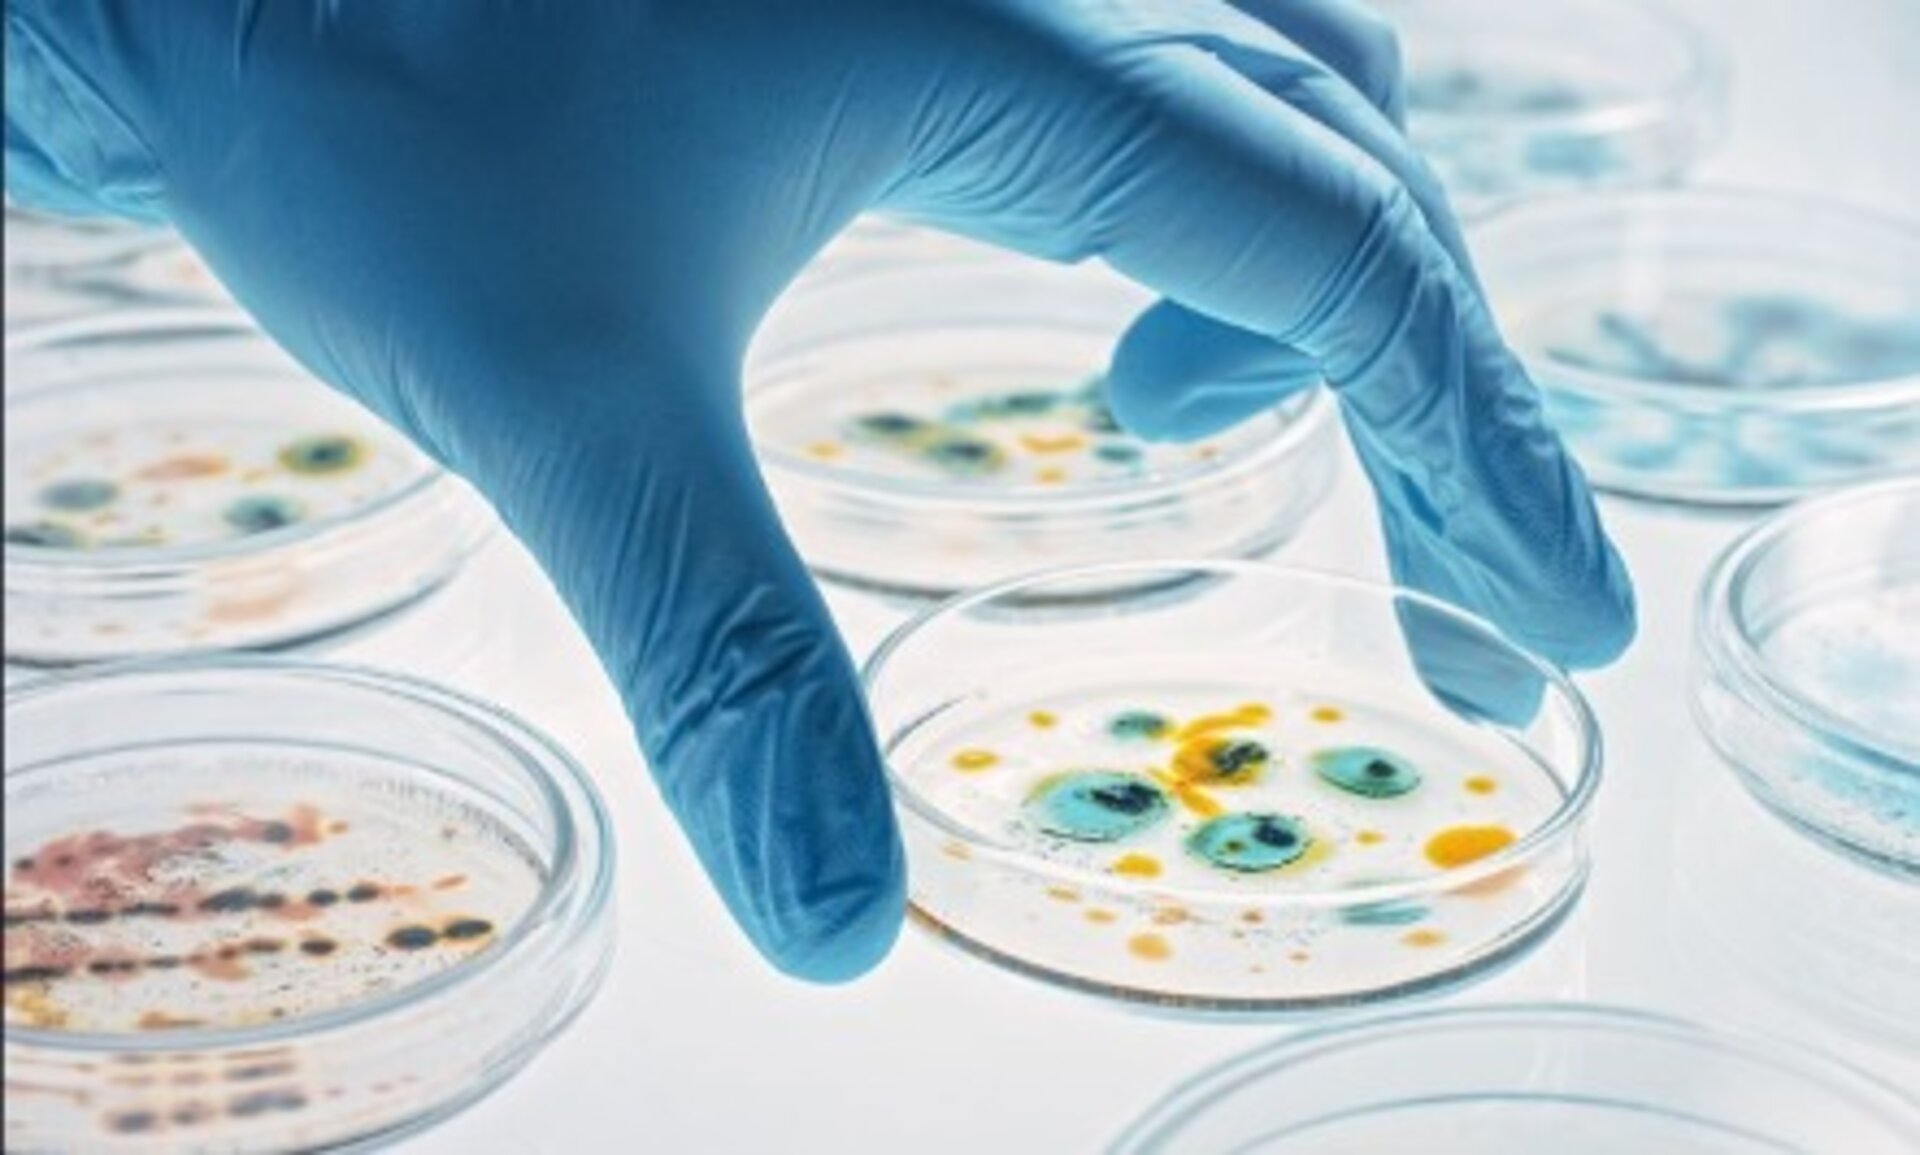

Important Dates
Article Submission
01 January - 30 September 2026
Arbitration
01 - 16 October 2026
Changes
17 - 24 October 2026
PPT Presentation
26 October 2026
Conference Video
27 October 2026
Preprint
28 November 2026
Scientific Program
10 December 2026